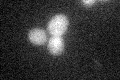
YJR035W

View description
Protein involved in transcription-coupled nucleotide excision repair of UV-induced DNA lesions; recruitment to DNA lesions is dependent on an elongating RNA polymerase II; homolog of human CSB protein
Localization:
Intensity:
Fold change:
Significance:
-
C’ GFP library in SD

below threshold16.85 -
N' NOP1pr-GFP in SD

nucleus71.6829 -
N' TEF2pr-mCherry in SD

nucleus62.037 -
N' NATIVEpr-GFP in SD

nucleus20.9148 -
N' TEF2pr-VC and Cyto-VN in SD

nucleus37.2577 -
C’ GFP library in SD+DTT
cytosol13.820.81No -
C’ GFP library in SD+H2O2

cytosol18.351.08No -
C’ GFP library in Starvation Media

nucleus16.560.98No -
C’ GFP library on the background of Pup2-DaMP

below threshold -
C’ GFP library on the background of CCT mutant

below threshold18.62851.10471No
